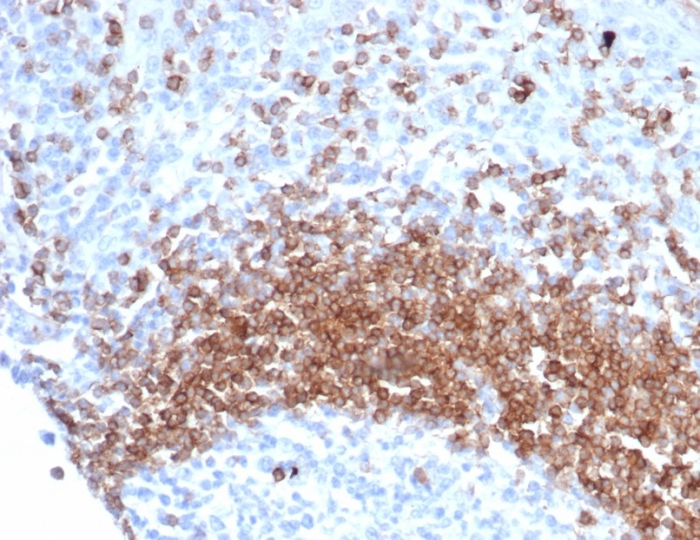
IgD Antibody (IGHD/6818R)

IgD Antibody (IGHD/6818R)
Novus Biologicals, part of Bio-Techne | Catalog # NBP3-20662
Recombinant Monoclonal Antibody


Conjugate
Catalog #
Forumulation
Catalog #
Key Product Details
Species Reactivity
Human
Applications
Immunohistochemistry-Paraffin
Label
Unconjugated
Antibody Source
Recombinant Monoclonal Rabbit IgG Kappa Clone # IGHD/6818R
Concentration
0.2 mg/ml
Product Specifications
Immunogen
Recombinant fragment (around aa1-200) of human IgD protein (exact sequence is proprietary)
Localization
Cytoplasm.
Clonality
Monoclonal
Host
Rabbit
Isotype
IgG Kappa
Description
Positive Controls: Human tonsil lysate or NAMALWA cell lysate. Human tonsil and lymphoid tissues
Antibody with azide - store at 2 to 8C. Antibody without azide - store at -20 to -80C. Non-hazardous. No MSDS required.
Antibody with azide - store at 2 to 8C. Antibody without azide - store at -20 to -80C. Non-hazardous. No MSDS required.
Scientific Data Images for IgD Antibody (IGHD/6818R)
IgD Antibody (IGHD/6818R)
Formalin-fixed, paraffin-embedded human lymph node stained with IgD antibody (IGHD/6818R). Inset: PBS instead of primary antibody; secondary only negative control.IgD Antibody (IGHD/6818R)
Formalin-fixed, paraffin-embedded human tonsil stained with IgD antibody (IGHD/6818R). Inset: PBS instead of primary antibody; secondary only negative control.Applications for IgD Antibody (IGHD/6818R)
Application
Recommended Usage
Immunohistochemistry-Paraffin
1-2 ug/ml
Application Notes
Immunohistochemistry (Formalin-fixed): 1-2ug/ml for 30 minutes. at RT. Staining of formalin-fixed tissues requires heating tissue sections in 10mM Tris with 1mM EDTA, pH 9.0, for 45 min at 95C followed by cooling at RT for 20 minutes.
Optimal dilution for a specific application should be determined.
Optimal dilution for a specific application should be determined.
Formulation, Preparation, and Storage
Purification
Protein A or G purified
Formulation
1mM PBS with 0.05% BSA
Preservative
0.05% Sodium Azide
Concentration
0.2 mg/ml
Shipping
The product is shipped with polar packs. Upon receipt, store it immediately at the temperature recommended below.
Stability & Storage
Store at 4C. Do not freeze.
Background: IgD
Long Name
Immunoglobulin D
Alternate Names
Igh-5, Ighd, Immunoglobulin Delta
Gene Symbol
IGHD
Additional IgD Products
Product Documents for IgD Antibody (IGHD/6818R)
Product Specific Notices for IgD Antibody (IGHD/6818R)
This product is for research use only and is not approved for use in humans or in clinical diagnosis. Primary Antibodies are guaranteed for 1 year from date of receipt.
Loading...
Loading...
Loading...
Loading...